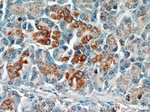
ST7 Antibody in Immunohistochemistry (Paraffin) (IHC (P))
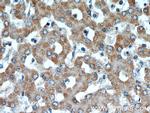
ST7 Antibody in Immunohistochemistry (Paraffin) (IHC (P))

Search
Proteintech
ST7 Polyclonal Antibody
{{$productOrderCtrl.translations['antibody.pdp.commerceCard.promotion.promotions']}}
{{$productOrderCtrl.translations['antibody.pdp.commerceCard.promotion.viewpromo']}}
{{$productOrderCtrl.translations['antibody.pdp.commerceCard.promotion.promocode']}}: {{promo.promoCode}} {{promo.promoTitle}} {{promo.promoDescription}}. {{$productOrderCtrl.translations['antibody.pdp.commerceCard.promotion.learnmore']}}
产品信息
11945-1-AP
种属反应
已发表种属
宿主/亚型
分类
类型
抗原
偶联物
形式
浓度
规格
纯化类型
保存液
内含物
保存条件
运输条件
产品详细信息
Immunogen sequence: LRPLLGGVD NNSSNNSDSN RQSVSECKVW RNPLNLFRGA EYNRYTWVTG REPLTYYDMN LSAQDHQTFF TCDSDHLRPA DAIMQKAWRE RNPQARISAA HEALEINECA TAYILLAEEE ATTIAEAEKL FKQALKAGDG CYRRSQQLQH HGSQYEAQHR RDTNVLVYIK RRLAMCARRL GRTREAVKMM RDLMKEFPLL SMFNIHENLL EALLELQAYA DVQAVLAKYD DISLPKSATI CYTAALLKAR AVSDKFSPEA ASRRGLSTAE MNAVEAIHRA VEFNPHVPKY LLEMKSLILP PEHILKRGDS EAIAYAFFHL AHWKRVEGAL NLLHCTWEGT FRMIPYPLEK GHLFYPYPIC TETADRELLP SFHEVSVYPK KE (101-481 aa encoded by BC030954)
靶标信息
The gene for this product maps to a region on chromosome 7 identified as an autism-susceptibility locus. Mutation screening of the entire coding region in autistic individuals failed to identify phenotype-specific variants, suggesting that coding mutations for this gene are unlikely to be involved in the etiology of autism. The function of this gene product has not been determined. Transcript variants encoding different isoforms of this protein have been described.
仅用于科研。不用于诊断过程。未经明确授权不得转售。
生物信息学
蛋白别名: 4low density lipoprotein-related protein 12; family with sequence similarity 4, subfamily A, member 1; family with sequence similarity 4, subfamily A, member 2; mRay; Protein FAM4A1; Protein HELG; suppression of tumorigenicity 7 (breast); Suppressor of tumorigenicity 7 protein; unnamed protein product
基因别名: 9430001H04Rik; ETS7q; FAM4A; FAM4A1; Fam4a2; HELG; RAY1; SEN4; ST7; TSG7
UniProt ID: (Human) Q9NRC1, (Mouse) Q99M96
Entrez Gene ID: (Human) 7982, (Mouse) 64213